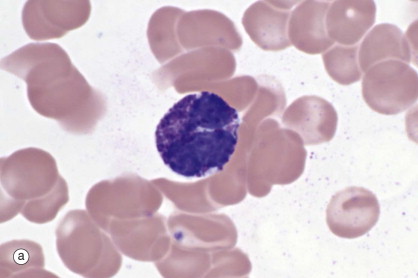

Name the 5 isotypes of Ig and what each is specialised for.
IgM - First responder. Activates classical pathway of complement cascade.
IgA - present in mucosa. Neutralises
IgG - Most common. Neutralises and opsonises. Antibody dependent cell-mediated cytotoxicity (ADCC); flag for NK cells
IgE - Elevated in parasitic infections and allergy. Degranulation.
IgD - rarest. Expressed on B cells
What type of ttissue is this?

Skeletal muscle
Which three substances mediate vasodilation in inflammation?
Histamine, NO, prostaglandin PGE2
What is the function of glycoproteins of the basement membrane? What is an example of a glycoprotein?
They anchor integrins of epithelial cells to ECM of the underlying connective tissue.
Example: Laminin 5 which links integrins from epitehlial cells

What is the structure of elastin?
Made of an elastin core surrounded by network of fibrilin myofibrils
Name these ligaments

A Supraspinous ligament
B Ligamentum flavum
C Posterior longitudinal ligament
D Anterior longitudinal ligament
Name these ligaments

A Supraspinous ligament
B Ligamentum flavum
C Posterior longitudinal ligament
D Anterior longitudinal ligament
What are the 4 functions of surface epitheliia?
Protection
Selective barrier
Absorption
Secretion
What type of fibres is elastin made of?
Thin and branched
Name 6 locations where stratified squamous epithelium is found
Skin (keratinised)
Oral cavity
Oesophagus
Vagina
Anus
Ectocervix
What type of WBC is this?

Eosinophil
Name 2 types of mononuclear leukocytes. Describe their cell lineage. What progenitor cells are they each derived from?
HSC –> MPP –> CLP –> lymphocytes T, NK and B cells (& Dendrites)
HSC –> MPP –> CMP –> Granulocyte monocyte progenitor –> Monocyte progenitor –> monocyte
HSC= haematopoeitic cell MPP= multipotent progenitor
CLP= common lymphoid progentior
CMP= common myeloid progenitor

Define autolysis
Why is it relevant to a pathologist?
How is it remedied?
When cells are removed from body, they start to break down almost immediately (autolysis).
This would make it hard for pathologist to know whether the tissue was pathological before biopsy.
Treat with formalin to fix the tissue and prevent autolysis; or cool tissue to slow autolysis
An acidophilic tissue will have an affinity for which dye?
Eosin
What is type III collagen also known as?
Reticulin
What type of WBC is this?
Basophil
Which two forces (and in which direction) are responsible for oedema in inflammation?
1 Increased hydrostatic pressure
2 Decreased coloidal osmotic pressure
Define nucleocapsid
The capsid most closely associated with the viral nucleic acid.
Nucleic acid + capsid
List 5 features of slow twitch fibres (Type I)
1 for running a marathon;
2 red because of many mitochondria;
3 aerobic respiration;
4 resist fatigue;
5 low tension developed.
What is the function of myoepithelial cells?
surround some exocrine glands to squeeze out contents
What type of WBC is this?

Monocyte
What is the size of a virus?
0.02 - 0.04 um
= 20 - 40 nm
Explain the physiologic basis of muscle contraction
Nerve impulse depolarises cell membrane.
T tubules conduct AP from membrane to SR.
AP causes SR to release Ca2+
Actin and myosin detach and reattach to each other, pulling Z discs closer together to shorten sarcomere.
What colour will an eosinophilic structure stain?
Pink/orange






































